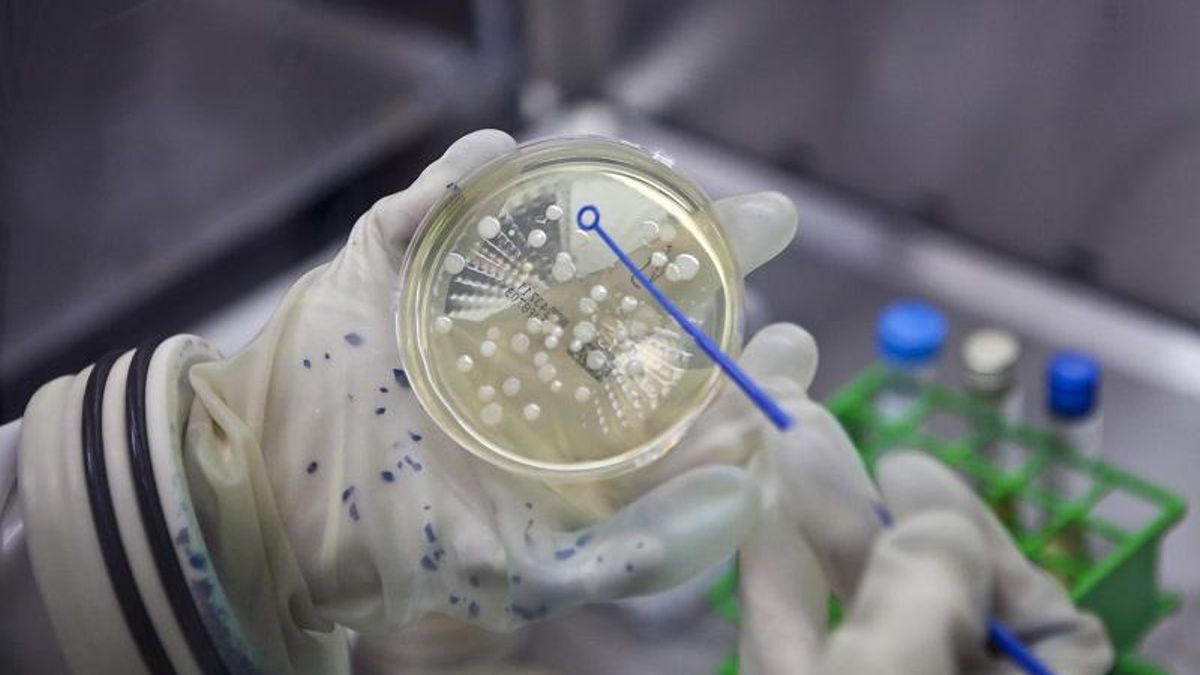
La región espera convertirse en centro infusor de terapias oncológicas CAR-T.

Extremadura pide al Ministerio ser centro para terapias oncológicas CAR-T antes de 2028
La Junta de Extremadura ha elevado una petición ante el Ministerio de Sanidad para convertirse, antes de 2028, en centro infusor de terapias oncológicas CAR-T, que actualmente obligan a los pacientes extremeños a desplazarse fuera de la comunidad.
Se trata de un tipo de tratamiento avanzado que implica la modificación genética de las células del propio paciente para ayudar a atacar a las células cancerosas.
En declaraciones con motivo de su participación en el Consejo Interterritorial del Sistema Nacional de Salud (CISNS), la consejera de Salud y Servicios Sociales, Sara García Espada, ha expresado que Extremadura está autorizando el doble de estos tratamientos con respecto a 2023. “Vamos a hacer un esfuerzo para conseguir la acreditación y que los extremeños puedan recibirlos sin salir de la región”, ha subrayado. A su juicio, “no vamos a esperar a 2028, que sería la nueva convocatoria, y agradeceríamos al Ministerio su colaboración”, ha dicho la consejera en el pleno del CISNS.
Por otro lado, según recoge la Junta en nota de prensa, Extremadura ha solicitado la acreditación del máximo de plazas de la nueva especialidad de Medicina de Urgencias y Emergencias que ha permitido el Ministerio, dos en las unidades docentes de Badajoz y Cáceres, para la próxima convocatoria MIR. “Nos parecen claramente insuficientes, pero Extremadura no se va a quedar atrás, y desde la primera convocatoria 2025-2026 ofertaremos estas plazas de forma pionera”, ha afirmado la consejera.
Asimismo, ha dicho que, por primera vez, Extremadura cumple los requisitos para acceder a la financiación estatal de plazas en facultades de Medicina, puesto que hasta ahora era la única comunidad autónoma excluida de esta línea de apoyo, “aun habiendo aumentado las plazas de medicina de 120 a 138”. “Hemos corregido una situación de absoluta incompetencia heredada del anterior gobierno y hoy he solicitado a la ministra que nos incluya en la financiación del próximo curso 2025-2026. Ya cumplimos los requisitos. No tenemos tiempo que perder”, ha relatado.
En este sentido, ha agradecido el trabajo conjunto con la Consejería de Educación y la Universidad de Extremadura para lograrlo.
Por otro lado, ha denunciado un “trato discriminatorio” hacia las facultades de Enfermería en la propuesta ministerial de ampliación de plazas “recibida 24 horas antes del CISNS de hoy”.
La responsable extremeña de Salud ha exigido que se aplique el mismo criterio y financiación que se ha utilizado para Medicina. García Espada también se ha referido al Plan de Acción de Salud Mental cuya petición de incluir a los colegios profesionales en la Comisión Técnica del Plan ha sido admitida por el Ministerio, que ha decidido sea a través de la invitación a la Unión Profesional, según el Ejecutivo extremeño.





0